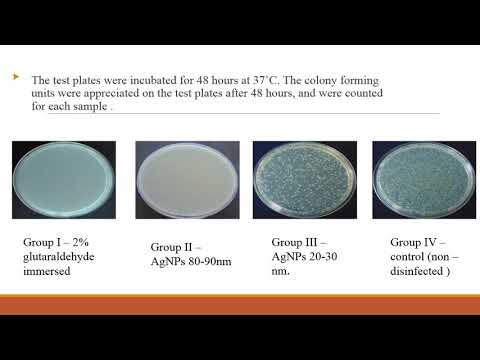

Conf Regd No: M474

Conf Regd No: M30

Conf Regd No: M50

Conf Regd No: M363

Conf Regd No: M47

Conf Regd No: M735

Conf Regd No: M679

Conf Regd No: M713

Conf Regd No: M580

Conf Regd No: M171

Conf Regd No: M699

Conf Regd No: M676
Conf Regd No: M630

Conf Regd No: M584

Conf Regd No: M617

Conf Regd No: M365

Conf Regd No: M492

Conf Regd No: M228
